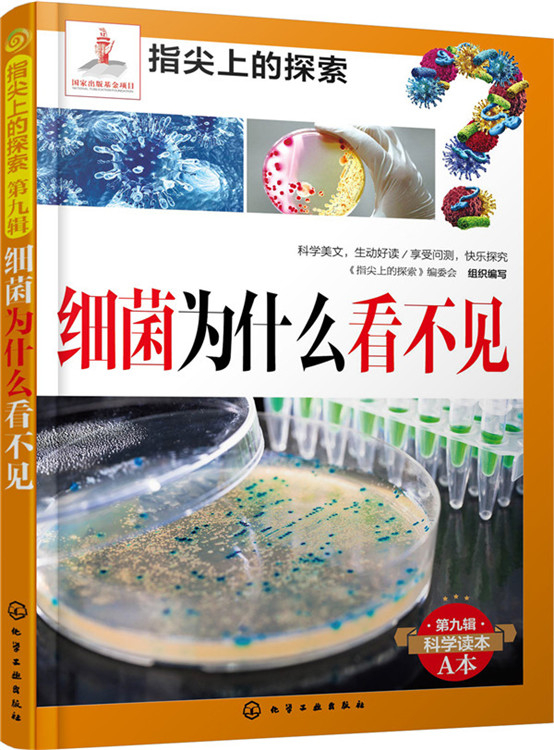

绘本故事《指尖上的探索:细菌为什么看不见(附显隐灯)》- 适合
绘本《指尖上的探索:细菌为什么看不见(附显隐灯)》,化学工业出版社
绘本内容
《指尖上的探索》编委会
编委会顾问:
戚发轫 国际宇航科学院院士、中国工程院院士
刘嘉麒 中国科学院院士、中国科普作家协会理事长
朱永新 中国教育学会副会长
俸培宗 中国出版协会科技出版工作委员会主任
编委会主任:
胡志强 中国科学院大学
编委会委员:(以姓氏笔划为序)
王小东 北方交通大学附属小学
王开东 张家港外国语学校
王思锦 北京市海淀区教育研修中心
王素英 北京市朝阳区教育研修中心
石顺科 中国科普作家协会
史建华 北京市少年宫
吕惠民 宋庆龄基金会
刘兵 清华大学
刘兴诗 中国科普作家协会
刘育新 科技日报社
李玉先 教育部教育装备研究与发展中心
吴岩 北京师范大学
张文虎 化学工业出版社
张良驯 中国青少年研究中心
张培华 北京市东城区史家胡同小学
林秋雁 中国科学院大学
周伟斌 化学工业出版社
赵文喆 北京师范大学实验小学
赵立新 中国科普研究所
骆桂明 中国图书馆学会中小学图书馆委员会
袁卫星 江苏省苏州市教师发展中心
贾欣 北京市教育科学研究院
徐岩 北京市东城区府学胡同小学
高晓颖 北京市顺义区教育研修中心
覃祖军 北京远程教育专业委员会
路虹剑 北京市东城区教育研修中心